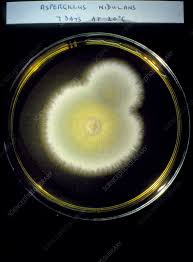
<p>What is this?</p>

Fungi n Mushroom names
1/19
There's no tags or description
Looks like no tags are added yet.
Name | Mastery | Learn | Test | Matching | Spaced |
|---|
No study sessions yet.
20 Terms

What is this?
Batrachochytrium dendrobatidis (chytrid)

What is this?
Pilobolus, hat thrower fungi (zygomycetes)
Known as the ‘‘fly killer’’
Entomophthora muscae (zygomycetes)

What is this?
Rhizopus stolonifer (zygomycetes)

What is this?
Glomus mosseae (glomeromycetes)

What is this?
Sacchromyces cerevisiae (asomycetes)

What is this?
Morchella esculenta (asomycetes)

What is this?
Cup Fungi (asomycetes)

What is this?
Tuber melanosporum (asomycetes)
What is this?
Aspergillis (asomycetes)

What is this?
Honey mushroom (basidiomycetes)

What is this?
Stink mushroom (basidiomycetes)

What is this?
Fly amanita mushroom (basidiomycetes)

What is this?
Calvatia gigantea (basidiomycetes)

What is this?
Jelly fungi (basidiomycetes)

What is this?
Earth stars (basidiomycetes)

What is this?
Trametes versicolor, shelf fungi (basidiomycetes)
Ringworm
Tinea corpis
Althlete’s foot
Tinea pedis
St Anthonie's Fire (Ergotism)
Claviceps purpurea (ergot)